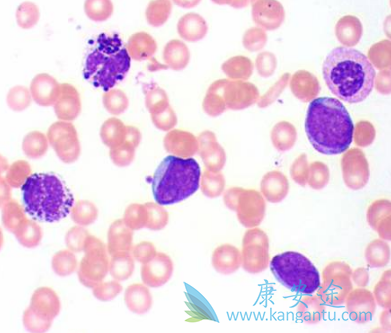
尼洛替尼 尼洛替尼

尼洛替尼(Nilotinib)获批治疗1岁及大于1岁的儿童慢性粒细胞白血病患者是基于CAMN107A2120和CAMN107A2203两项临床试验。这些患者可以是新诊断的Ph染色体阳性且处于慢性期者,也可以是以往经过酪氨酸激酶抑制剂治疗却发生耐药或不耐受者。这两个实验中的患者均接受了尼洛替尼230 mg/m2每日两次的剂量(最大单次剂量为400mg),28天为一疗程。
尼洛替尼(Nilotinib)中位治疗时间为13.8个月(0.7-30.9个月)。耐药或不耐受的Ph染色体阳性的儿童慢性粒细胞白血病慢性期患者,12疗程MMR(BCR-ABL/ABL ≤0.1% IS)40.9% (18/44) ;新诊断的儿童慢性粒细胞白血病慢性期患者12疗程MMR 60.0% (15/25)。在耐药或不耐受的Ph染色体阳性的儿童慢性粒细胞白血病慢性期患者中,4.5%的患者在截止日期前达到了BCR-ABL/ABL ≤0.0032% IS (MR4.5)。在新诊断的儿童慢性粒细胞白血病患者中,有28%达到MR4.5。
在儿童用药的安全性方面,和成人慢性粒细胞白血病慢性期患者相似。最常见的3/4级副反应为ALT升高和高胆红素血症。17名病人观察到QTc间期比基线延长超过30毫秒。没有病人出现QTc间期绝对值超过500毫秒或者超过基线60毫秒以上。尼洛替尼(Nilotinib)的儿童用药剂量为230 mg/m2,每日两次,口服,最大单次剂量为400mg。
详情请访问 肿瘤 https://www.kangantu.com/














请简单描述您的疾病情况,我们会有专业的医学博士免费为您解答问题(24小时内进行电话回访)